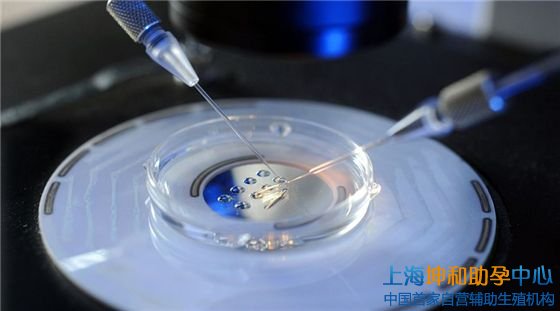

据相关数据显示,有三分之一的女性患有肌瘤,多发生在女性育龄期,是导致女性不孕或流产的主要原因之一。试管婴儿可以说是子宫肌瘤女性提高妊振率的最有效途径,也是健康生育的理想途径。那么,宫颈肌瘤在什么位置不会影响试管婴儿成功率呢?
宫颈肌瘤对生育的影响
在临床上,宫颈肌瘤的症状不仅包括子宫出血、疼痛、白带、腹部肿块及压迫、贫血等常见的不良症状,而且对女性的生育能力有一定的影响。专家表示,宫颈肌瘤对女性生育能力的影响与肌瘤的位置、大小、数量和形状密切相关。即:
1、部位:根据宫颈肌瘤的部位可分为粘膜下肌瘤、浆膜下肌瘤、壁内肌瘤、宫颈肌瘤等。一般来说,受精卵在子宫角生长时会阻碍受精卵的通过,在子宫内膜生长时会影响胚胎着床,导致不孕。详情请咨询:专业国际医疗顾问13262761222或13262761222/ 微信同步
2、大小及数量:子宫肌瘤直径大于5cm或子宫肌瘤数量大于5cm,不仅会加重腹痛、月经增多、月经不停的症状,还会扭曲子宫腔或压迫周围器官,阻碍妊娠囊的着床和胚胎的发育,导致胚胎生长发育受限、胎位异常、流产等。粘膜下肌瘤可阻止妊娠囊或精子着床进入宫腔。肌瘤患者的自然流产率高于正常人,比例约为4:1。
3、形态结构:肌瘤可引起肌壁和子宫内膜静脉充血、扩张,子宫收缩功能障碍,宫腔形态结构改变,并可引起肌瘤变性,降低着床率、妊娠率和分娩率,增加早产风险,难产和产后出血。
因此,针对宫颈肌瘤对女性生育能力的影响,对于宫颈肌瘤女性赴美进行试管检查,上海坤和专家将根据她们的具体情况,在保证女性健康和安全的前提下,利用美国先进的试管婴儿技术,制定出具体方案,提高成功率,同时照顾母婴健康。
宫颈肌瘤试管婴儿成功率?
针对这一问题,上海坤和专家的回答和建议是:根据女性的身体状况,我们可以先进行促排。取出卵子后,与精子结合受精,通过基因筛选培育获得健康的囊胚,然后冷冻保存,等待肌瘤治疗、身体恢复和解冻移植,以提高试管婴儿的成功率。.
情况1
宫颈肌瘤直径小,数目少,无明显症状,无需手术治疗。女性只需定期做体格检查,详细掌握宫颈肌瘤的生长情况,然后用药物对症治疗,可有效抑制肌瘤的生长。当子宫及身体各方面状况与妊娠期一致时,应解冻移植囊胚,并对整个妊娠期进行跟踪监测。<< 做试管去哪儿好,资深生殖科医生出方案
情况2
如果女性宫颈肌瘤直径大于5cm,导致月经过多和贫血,或多发子宫肌瘤,使整个子宫变大,且肌瘤生长很快,则属于严重的子宫肌瘤。这时,就要采取手术、肌瘤切除和调理,待康复后,达到怀孕的要求并保持怀孕。然后,对囊胚进行解冻移植,以提高胎儿的着床率。
建议宫颈肌瘤如经手术诊治,至少三个月以上,方可移植妊娠,症状严重者至少应等待半年。此外,对于年龄较大、卵巢功能下降的女性,建议尽快赴美,抓住帮助怀孕的机会,实现生育梦想。
情况3
如果肌瘤病情非常严重,药物不能达到疗效,或者术后子宫创伤大,子宫内膜损伤严重,不利于囊胚成功植入,妊娠后流产的几率也很大,或者做子宫切除术等。在这方面,上海坤和专家建议,对于不能自己怀孕的妇女性,可以在美国合法第三方的帮助下,完成怀孕计划,获得一个健康的婴儿。
因此,对于一个患有子宫肌瘤的女性朋友来说,想要孩子的夙愿并不是梦。可以去美国做试管妊娠,并积极配合专家进行诊断和治疗,好孕即将来临。
以上就是关于宫颈肌瘤美国试管婴儿的介绍了,希望对您有所帮助!上海坤和助孕中心始终践行在辅助生殖领域的行业规范、健康发展的道路上,通过引进生殖领域博士人才、完善人性化服务体系,不断提高自身辅助生殖医疗水平,不仅在业内树立了良好的形象,同时也深受试管婴儿患者的好评。
>>>如果您想了解更多关于“美国第三代试管婴儿”、“代生怀孕”、“供卵试管”、“PGD/PGS技术”、“代怀孕价格费用”、“第三方辅助生殖助孕”等方面的资讯,可以拨打13262761222或添加本电话号码的微信号联系坤和生殖顾问。

|
| 2025山东试管婴儿费用是多少?成功率高不高? |

|
| 三代试管成功率有多高? |

|
| 试管一般需要做几次能成功?试管成功率受到哪些因素的影响? |

|
| 多次流产做试管婴儿成功率高不高?需要多少钱? |

|
| 试管移植后14天内食谱,如何提高试管着床成功率? |

|
| 试管冻胚移植成功率有多少,会受到哪些因素的影响呢? |

